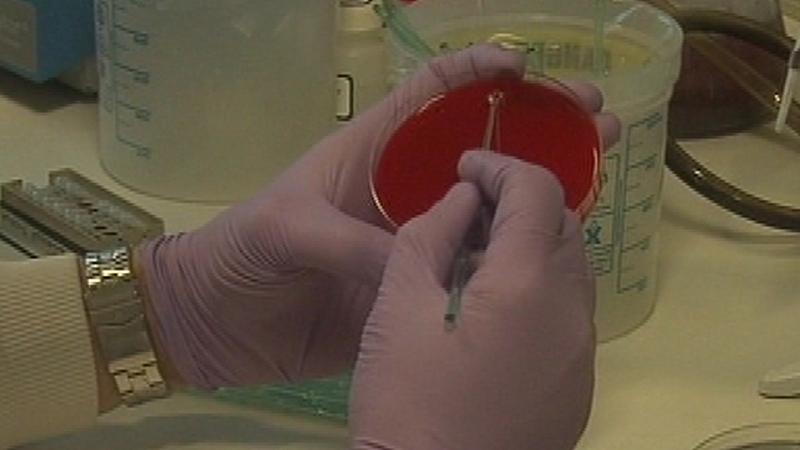
Main symptoms in children are a rash, high temperature and irritability

A leading paediatrician has said parents should seek urgent medical advice if their children show any of the signs of meningitis.
Today is World Meningitis Awareness Day and the disease affects between 50 and 60 people in Ireland each year, which is the highest rate in western Europe.
Speaking on RTÉ's Morning Ireland, Consultant Paediatrician at Temple Street Hospital Professor Alf Nicholson said even though a vaccination campaign has reduced cases of the disease, parents should remain vigilant.
He said the main symptoms in children are a rash, high temperature and irritability, although a rash is present in only 80% of cases.
Prof Nicholson said: "If you feel your young baby is off form and not him or herself and maybe has a rash you should seek medical attention urgently.
"There is this concept of the 'golden hour', so the earlier the treatment the better."
Prof Nicholson said that Ireland has the lowest mortality rate from the disease, but it can leave sufferers with permanent scars.
He said: "It can cause deafness. It can cause mental handicap, seizures and epilepsy. There are plenty of after-effects of meningitis. Sometime the rash can become so bad it can cause significant scarring or loss of fingers."
Prof Nicholson said a new vaccine to combat the Meningococcal B form of the disease has been licensed in Europe and he hopes it could soon be available in Ireland.